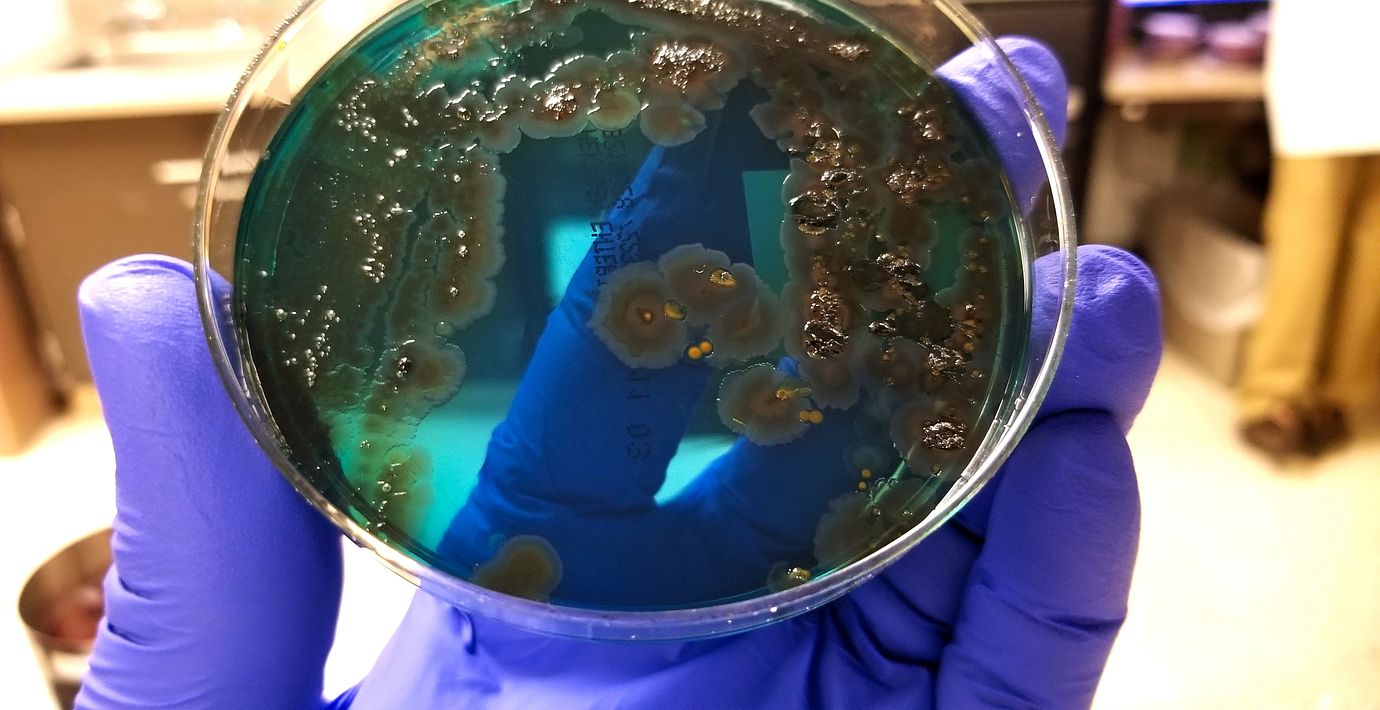

Chromogenics rusar 70 procent efter storägarens bud
Chromogenics rusade på First North efter morgonens besked att storägaren Gerald Engström lägger ett bud på bolaget.
Budet som läggs via Engströms ägarbolag Färna Invest uppgår till 10 kronor per aktie.
Aktien rusade nära 70 procent till strax under budnivån.
Omni är politiskt obundna och oberoende. Vi strävar efter att ge fler perspektiv på nyheterna. Har du frågor eller synpunkter kring vår rapportering? Kontakta redaktionen